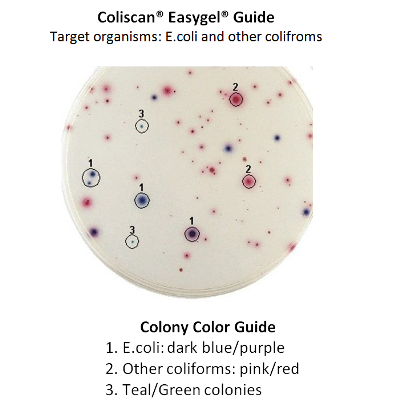

-
ΈκπτωσηEasygel Restaurant Swab Kit
Κανονική τιμή $100.00Κανονική τιμήΤιμή μονάδας ανά$299.00Τιμή έκπτωσης $100.00Έκπτωση -
ΈκπτωσηEnzyme Eaters
Κανονική τιμή $45.95Κανονική τιμήΤιμή μονάδας ανά$60.00Τιμή έκπτωσης $45.95Έκπτωση -
Glowing Detective - Science Project Kit
Κανονική τιμή $48.95Κανονική τιμήΤιμή μονάδας ανά$60.00Τιμή έκπτωσης $48.95Έκπτωση -
Membrane Water Filter Test Kit E. Coli Coliforms
Κανονική τιμή $100.00Κανονική τιμήΤιμή μονάδας ανά$299.00Τιμή έκπτωσης $100.00Έκπτωση -
Microbes Microbiology Liquids _ Water Science Fair Experiments
Κανονική τιμή $100.00Κανονική τιμήΤιμή μονάδας ανά$299.00Τιμή έκπτωσης $100.00Έκπτωση -
Microbiology Antibiotic Effects Science Fair Projects Kit
Κανονική τιμή $100.00Κανονική τιμήΤιμή μονάδας ανά$299.00Τιμή έκπτωσης $100.00Έκπτωση -
Microscope Bundle
Κανονική τιμή $655.95Κανονική τιμήΤιμή μονάδας ανά$655.00Τιμή έκπτωσης $655.95 -
ΈκπτωσηMystery Powder Forensic Lab
Κανονική τιμή $19.95Κανονική τιμήΤιμή μονάδας ανά$25.00Τιμή έκπτωσης $19.95Έκπτωση -
Mystery Volume Lab and Graduated Cylinder
Κανονική τιμή $15.95Κανονική τιμήΤιμή μονάδας ανά$25.00Τιμή έκπτωσης $15.95Έκπτωση -
Ooey Gooey Chemistry Student Workbook
Κανονική τιμή $23.95Κανονική τιμήΤιμή μονάδας ανά$45.50Τιμή έκπτωσης $23.95Έκπτωση -
Ooey Gooey Chemistry Teacher's Edition
Κανονική τιμή $46.95Κανονική τιμήΤιμή μονάδας ανά$60.95Τιμή έκπτωσης $46.95Έκπτωση -
Squishy Circuits Deluxe Kit – ElectricityElectronics Science Fair Projects
Κανονική τιμή $100.00Κανονική τιμήΤιμή μονάδας ανά$299.00Τιμή έκπτωσης $100.00Έκπτωση